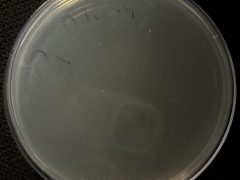
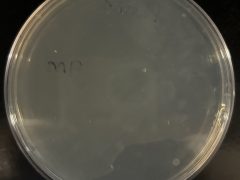

Description
Soil looked dry
Data for Soil Sample and Researcher
Location of Soil Sample
38 Almeda Rd, Houston, TX 77004, USA, 38 Almeda Road, Houston, Texas 77004, United States, 29.713418, -95.38289
Collection Date of Soil Sample
Colonies of Paraoxon
300
Paraoxon Count May Not Be Exact
Yes
Colonies of Methyl Parathion
300
Methyl Parathion May Not Be Exact
Yes
Researcher
Mary Adwer
Organization
University of Houston
Lab Day
Monday
Time of Lab
4:00 PM
Course Term
Summer
Year of Course
2024
Image Descriptions in General
Samples in minimal media for 5 weeks (week 1, week 2, week 3, week 5)
Plates exhibited over growth of colonies since the culture were NOT diluted.
Extended Analysis Results
Cataloged
No
Degradation Kinetics
Screenshot-2024-08-05-at-10.09.51 -1.png-1 Screenshot-2024-08-05-at-10.09.57 -1.png-1 Screenshot-2024-08-05-at-10.10.02 -2.png-2 Screenshot-2024-08-05-at-10.10.06 -1.png-1 Screenshot-2024-08-05-at-10.10.12 -1.png-1 Screenshot-2024-08-05-at-10.10.15 -2.png-2 Screenshot-2024-08-05-at-10.09.57 -5.png-5 Screenshot-2024-08-05-at-10.09.57 -8.png-8